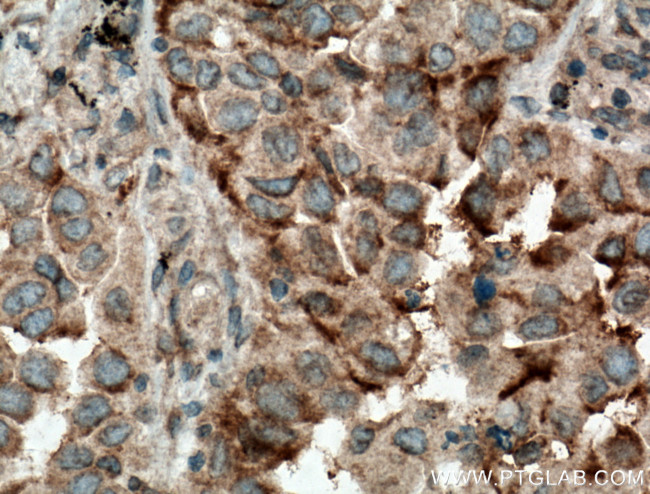
ARHGEF10 Antibody in Immunohistochemistry (Paraffin) (IHC (P))

Search
Proteintech
ARHGEF10 Polyclonal Antibody
{{$productOrderCtrl.translations['antibody.pdp.commerceCard.promotion.promotions']}}
{{$productOrderCtrl.translations['antibody.pdp.commerceCard.promotion.viewpromo']}}
{{$productOrderCtrl.translations['antibody.pdp.commerceCard.promotion.promocode']}}: {{promo.promoCode}} {{promo.promoTitle}} {{promo.promoDescription}}. {{$productOrderCtrl.translations['antibody.pdp.commerceCard.promotion.learnmore']}}
产品信息
11112-1-AP
种属反应
已发表种属
宿主/亚型
分类
类型
抗原
偶联物
形式
浓度
规格
纯化类型
保存液
内含物
保存条件
运输条件
产品详细信息
Immunogen sequence: YLNKLLSSG SRYLIRSDDM IETVYNDRGE IVKTKERRVF MLNDVLMCAT VSSRPSHDSR VMSSQRYLLK WSVPLGHVDA IEYGSSAGTG EHSRHLAVHP PESLAVVANA KPNKVYMGPG QLYQDLQNLL HDLNVIGQIT QLIGNLKGNY QNLNQSVAHD WTSGLQRLIL KKEDEIRAAD CCRIQLQLPG KQDKSGRPTF FTAVFNTFTP AIKESWVNSL QMAKLALEEN HMGWFCVEDD GNHIKKEKHP LLVGHMPVMV AKQQEFKIEC AAYNPEPYLN NESQPDSFST AHGFLWVRCV Y (342-641 aa encoded by BC036809)
靶标信息
This gene encodes a Rho guanine nucleotide exchange factor (GEF). Rho GEFs regulate the activity of small Rho GTPases by stimulating the exchange of guanine diphosphate (GDP) for guanine triphosphate (GTP) and may play a role in neural morphogenesis. Mutations in this gene are associated with slowed nerve conduction velocity (SNCV). Alternative splicing results in multiple transcript variants.
仅用于科研。不用于诊断过程。未经明确授权不得转售。
生物信息学
蛋白别名: KIAA0294; Rho guanine nucleotide exchange factor (GEF) 10; Rho guanine nucleotide exchange factor 10
基因别名: 6430549H08Rik; ARHGEF10; GEF10; KIAA0294; mKIAA0294; RGD1565043; SNCV
UniProt ID: (Human) O15013, (Mouse) Q8C033
Entrez Gene ID: (Human) 9639, (Mouse) 234094, (Rat) 306618